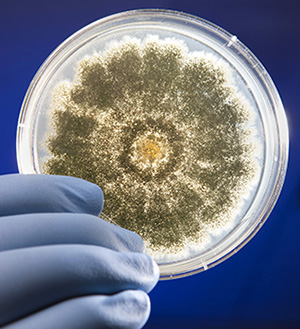

The Antimicrobial Benefits of Mushrooms
Due to the Radical Left Democrat shutdown, this government website will not be updated during the funding lapse. President Trump has made it clear he wants to keep the government open and support those who feed, fuel, and clothe the American people.
Petri dish containing the fungus Aspergillus flavus. This common fungus is a concern because it produces carcinogenic aflatoxins that may contaminate certain foods and cause aspergillosis, an invasive fungal disease. (Photo by Peggy Greb, D2162-1)
Scientists with the Agricultural Research Service (ARS) are examining the antimicrobial properties of mushroom extracts. Their goal: make food crops safer throughout the production process, from farm to fork – and beyond – including the ability to mitigate chronic human health conditions.
Mushrooms are a classic example of a two-sided coin. On one side, mushrooms are a valuable source of food and income around the world and are known to have pharmaceutical qualities. On the other, nearly 7,500 cases of mushroom poisoning (over 700 serious cases and 52 deaths) occur each year in the United States alone.
Now, researchers are pitting the good properties of mushrooms against the bad.
“Edible mushrooms [are] a source of bioactive compounds, and certain medicinal mushrooms have emerged as beneficial ingredients of dietary supplements,” said Jong H. Kim, molecular biologist at the ARS Foodborne Toxin Detection and Prevention Research unit in Albany, CA.
Kim is the primary author of a paper on how medicinal mushrooms contribute to food safety.
The role of mushrooms in food safety begins in the farmer’s field. According to Kim, pinecone cap mushrooms, which are a type of fungi, provide the main ingredient in the fight against a worldwide carcinogenic fungus – Aspergillus flavus.
A. flavus produces aflatoxins, some of the most dangerous mycotoxins that widely contaminate many major crops, such as corn, tree nuts, and peanuts. People who eat a large amount of food contaminated with aflatoxins – or products derived from animals that have eaten it – are at higher risk for some adverse health conditions, including liver cancer and stunting in children.
“Many antimicrobial agents have been developed from mushroom ingredients for crop protection, [including] the natural fungicide strobilurin,” Kim said. “Strobilurins [are] one of the most important classes of agricultural fungicide.”
When farmers use strobilurins, the compound inhibits A. flavus growth by interrupting its ability to breathe. Stopping A. flavus in the field reduces the amount of aflatoxins that manufacturers must contend with during food processing and packaging.
“[We] found that a component of the mushroom Taiwanofungus camphoratus (Tc) could be developed as a food ingredient having antimicrobial potential, thus inhibiting the growth of fungi and bacteria in foods,” Kim said. “Tc lowers the contamination rate of toxin-producing or heat-tolerant fungi that escape the food sanitation process. The application of Tc in the food industry will promote food safety, which is vital for the health of consumers.” – by Scott Elliott, ARS Office of Communications
You May Also Like: